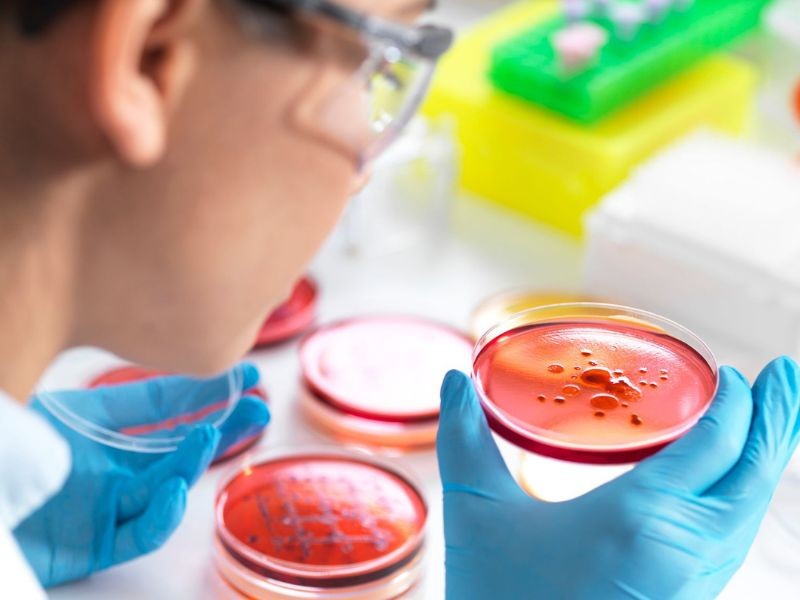

HigeyaLab
A qualidade dos alimentos que consumimos está diretamente ligada à nossa saúde e bem-estar. Por isso, garantir que produtos alimentícios estejam livres de contaminações e dentro dos padrões legais é essencial para indústrias, restaurantes, distribuidores e manipuladores de alimentos.
O HigeyaLab oferece um serviço completo para análise de alimentos, combinando rigor técnico, equipamentos de alta precisão e profissionais qualificados, para assegurar que seus produtos atendam às exigências de diversos órgãos fiscalizadores.
Realizamos ensaios microbiológicos e físico-químicos em alimentos, matérias-primas, além de utensílios, superfícies e mãos de manipuladores. Essas análises são fundamentais para identificar contaminações, avaliar o controle de qualidade e garantir a segurança dos processos produtivos.
Entre os principais ensaios realizados estão:
Análises microbiológicas
A análise microbiológica garante alimentos seguros, identificando e quantificando microrganismos que possam representar riscos à saúde do consumidor.
Análises bromatológicas
As análises bromatológicas revelam a composição nutricional dos alimentos, determinando nutrientes essenciais e garantindo a conformidade com padrões de qualidade e rotulagem.

Análises de Proteínas
As análises de proteínas determinam o teor de aminoácidos e proteínas totais dos alimentos, fornecendo informações essenciais para rotulagem nutricional, controle de qualidade e desenvolvimento de novos produtos.

Todas as análises seguem metodologias reconhecidas internacionalmente, como o Standard Methods for the Examination of Water and Wastewater (SMEWW) e as normas oficiais da Anvisa e do MAPA, assegurando rastreabilidade e precisão em cada etapa.
Os serviços de análise de alimentos são ideais para:
Indústrias alimentícias – controle de qualidade e liberação de lotes.
Restaurantes e cozinhas industriais – boas práticas e segurança alimentar.
Empresas de catering e buffets – monitoramento de higiene.
Produtores artesanais – regularização e rotulagem de produtos.
Supermercados e distribuidores – controle de armazenamento e validade.
Tipos de alimentos que podem ser analisados
Águas e bebidas (refrigerantes, sucos, cervejas, chás, isotônicos)
Laticínios (leite, queijos, iogurtes, manteigas, cremes)
Carnes e embutidos (bovinos, suínos, aves, linguiças, presuntos, salsichas)
Peixes e frutos do mar (filés, camarões, moluscos, conservas)
Produtos de panificação (pães, bolos, biscoitos, massas e farinhas)
Alimentos prontos e refeições congeladas
Doces e confeitaria (chocolates, balas, sobremesas, geleias)
Hortaliças, frutas e vegetais frescos ou processados
Grãos e cereais (arroz, feijão, milho, aveia, soja)
Produtos veganos e plant-based
Alimentos artesanais e caseiros (queijos, conservas, molhos, kombuchas)
Condimentos, temperos e molhos prontos
Óleos e gorduras vegetais e animais
Suplementos alimentares e produtos funcionais
Laboratório com infraestrutura moderna e equipamentos certificados.
Profissionais especializados.
Atendimento ágil e personalizado.
Relatórios claros, interpretativos e de acordo com a legislação vigente.
Compromisso com a segurança alimentar e a conformidade legal dos seus produtos.
📞 Entre em contato conosco e solicite seu orçamento.
Garanta a qualidade, segurança e confiança que seu alimento — e seu cliente — merecem.
Preencha o formulário abaixo e garanta a qualidade dos seus serviços
Análise de Alimentos
Veja o Feedback de nossos clientes sobre controle de qualidade da água, ar, superfícies e teste de autoclave
Av. Protásio Alves, 1324
Petrópolis, Porto Alegre - RS
CEP: 90410-005
Segunda a Sexta
09h às 18h
© Copyright 2025. DIVIA Marketing Digital. Todos os Direitos Reservados
